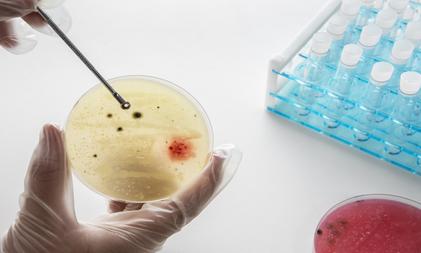
Airborne pathogens behind lung, gut infections 2x more in high-populated regions: Study

Showing results for "#pathogens"
Antimicrobial peptides can curb Salmonella, E. coli and help combat...
Antimicrobial peptides, which are short chains of amino acids, have the potential to kill harmful bacteria without inducing resistance to antibiotics
Study finds pathogens coerce immunity by using force
7 Dec 2023 12:45 PM ISTThe finding presents a potentially revolutionary approach to combating microorganisms that cause deadly infectious diseases like chlamydia, malaria,...
Various pathogens responsible for surge in acute respiratory illnesses...
27 Nov 2023 7:22 AM ISTNational Health Commission spokesman Mi Feng said the growth in cases was being driven by the influenza virus as well as rhinoviruses, mycoplasma...
New 'lab on a chip' device to accurately identify Covid, cancer in 3...
5 Nov 2023 2:50 PM ISTThe virus diagnosis device has been invented by engineers at the University of Bath, who describe it as the 'world's fastest Covid test'.
IIT Bombay’s device to detect viral & bacterial pathogens in...
19 Oct 2023 3:45 PM ISTIt functions by detecting colour changes in samples created by the interaction of DNA with methylene blue (MB) dye.
Climate change can alter risk of succumbing to infectious diseases
12 Sept 2023 2:58 PM ISTCombining data on occurrence with climatic factors revealed that the occurrence of most pathogens was associated with temperature or rainfall.
Time-travelling pathogens in melting permafrost may pose risk to...
30 July 2023 6:30 PM ISTThe researchers performed artificial evolution experiments where digital virus-like pathogens from the past invade communities of bacteria-like hosts.
How human immune system detects Covid
9 Jun 2023 4:28 PM ISTThe study, published in the journal PLOS Biology, described a previously unknown inflammasome immune protein known as CARD8.